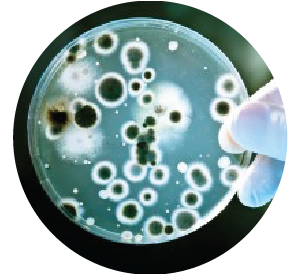

Palm Beach Day Academy
Throughout the Covid pandemic, our top priority was the re-opening of our campuses while ensuring the health and safety of our students, faculty, and staff. As a result of our partnership with RGF and the installation of their premier air purification technology in our buildings, we felt confident that we could safely execute our Opening of School plan and re-open our doors to our community.
— C.E. Palm Beach Day Academy
Mini-Split PHI unit
We installed a ductless system in our service department for both heating and air conditioning summer of 2016. The service office is next to our parts room which serves both install and service departments. Needless to say there is a steady traffic flow past the indoor unit and at times 6-8 service technicians in the same room the air conditioner. Within two months of the install of our air conditioner, unit blower wheel and evaporator coil blowing black debris across the office. Air filters where being cleaned monthly. We cleaned unit every two months and had to pull blower wheel out every time due to the excessive buildup of grim. For a year we did this same process and also had to treat / sanitize coil for dirty sock smell about every 3 months during air conditioning season. In 2017, we installed the PH230RGF UV light. We had previously installed several of these systems for our customers and want to put it to the test for ourselves. (Seeing is believing) and all my service technicians were sick of cleaning this unit in the office. Since the install of the PHI-230 we are back to a normal cleaning cycle of once every 6 months, blower wheel has not been pulled for 2 years and looks like new yet. Unit no longer needs sanitized for dirty sock smell. Out of the eight other indoor units, this unit is typically the cleanest unit, with the most foot traffic past it. Our service, sales, office and install staff can now see the difference between no UV light and having a UV light. Seeing is believing, our technicians are talking to more customers and selling more products due to they believe in the product. Having that peace of mind for our employees to talk to customers and make recommendations to improve IAQ at our customers’ homes and office is priceless. This only validates that we are not selling “smoke and mirrors” but we are selling products that work and we use them ourselves.
— K.W. Gary and Sons Inc.
A product that DELIVERS!
The REME-HALO has tremendously helped nullify or reduce dramatically pet and kitchen odors. However, I bought the unit for relief from allergy symptoms and the REME has been extraordinary on that front, too. I’ll buy another, in the future, I’m 100% sure. A product that DELIVERS!
— KJ Austin, TX
All I have to say is WOW!!!
I have been working in the HVAC world for years. I have seen products come & go but I have become a believer. I manage a duct cleaning crew & have a lot of questions sent to me about allergies, dust, mold, & how to keep a home as allergen free & dust free as possible. Once I found out about RGF I dove into the technology & decided to install a REME Halo into my own home BEFORE I sell a single unit. My home was built in the 1950’s, 3,000 sq feet home with 1,500 sq feet main floor & a matching basement. The HVAC system was installed in 1995 as a 3.5 ton AC & Furnace. 1 exterior door is sealed & the other is not. I have a mix of single pane wood framed windows & double paned fiberglass. It is not a completely sealed house YET. I also personally cleaned my own HVAC system not 2 years ago. Normally I change my 2 inch thick MERV 8 filter every 2 months. The pleated material looks the color of cardboard. 1 MONTH after I had installed the REME Halo the same filter, which was installed brand new with the REME Halo, the filter was dark brown like Hot Chocolate. I was Floored!! During that same month my outdoor only cat, which is fed right next to the unsealed exterior back door, was sprayed by a SKUNK!! The poor cat had a yellow line on her chest for weeks. This all happened while my family & dogs were inside asleep. By morning my whole house reeked of Skunk. So I went down to the basement, opened the REME Halo and opened the sleeve WIDE OPEN. To my amazement, the skunk odor that seept into my house was gone within 2 HOURS!!!!!! All I have to say is WOW!!! These products like the REME Halo have and continue to do their job. Great stuff!!! Oh & I am now selling them
— J.F. Manager Super Vac Division
Cedar Fever
I send you New Year’s greetings because of the Reme-Halo product. Normally at this time of the year, I would be very uncomfortable inside and out due to cedar fever but I am truly thankful to you for the introduction of the Reme-Halo into my life. Kim Saunders from ABC Home & Commercial Services installed the Reme-Halo in my home on 11/16/18 and I remembered from talking to you, Todd Montgomery, District Instructor for the Reme-Halo, that I should check my filters early after running my HVAC fan 24/7 since I didn’t have a newer programmable system. I changed those filters on Christmas Day as it was 2 months to the day, (I usually do it every 3 months) since they were changed. I thought you might appreciate a visual. So, so dirty after 2 months which I think means the Reme-Halo is doing its job. But even more importantly, I haven’t awakened in the middle of the night with a headache since soon after my Reme-Halo was installed. And when I have had a cedar spasm away from my home, once I was home, my immune system settled down and I didn’t feel bad. That is impressive to me as cedar has been a major problem to me for years. And that makes me thankful for the investment I made. I have shared my story with several people but I think the three of you ought to get together and create a TV ad that combines ABC Home and Commercial Services with RGF’s Reme-Halo. I have seen ABC’s ads on a variety of generic solutions but the Reme-Halo could help many more Austin homeowners if you would be more aggressive with telling your viewers the value of the Reme-Halo. I am so appreciative that I had Kim Saunders to my home who shared the technology with me and I appreciate that you, Todd Montgomery, took the time to help me understand your product. All Austin needs now is you, Bobby Jenkins, to do a commercial that tells Austinites the value of the Reme-Halo. I encourage the three of you to get together and make Austin residents more comfortable as the Reme-Halo has made me. Thank you for working together and I am sure this new year will bring more success to your businesses.
— Happy New Year! K.T.
7 Time Finnish Ice Hockey Champion, Oulun Kärpät, stays healthy with RGF’s PHI Technology.
Oulun Kärpät, the seven time Finnish champion ice hockey team from Northern Finland, protects its team against viruses, microbes and odors with RGF’s patented Photohydroionization® (PHI) technology. PHI is a chemical free, very effective and safe advanced oxidation gas used to treat air and equipment surfaces. With 30 players sharing a training facility and locker room eight hours a day, hygiene is very important. If one player gets sick, the rest are at risk and the team will suffer. To ensure a healthy team, Mariner Systems are mounted throughout the facility keeping the indoor air quality and surfaces clean and safe. In addition to maintaining excellent indoor air quality, it is also necessary to sanitize the equipment used by the players. In between the two ice training sessions each day, all of the gloves and boots are dried and sanitized on racks fitted with two RGF HVAC Minis reducing odors and microbes. RGF’s PHI technology helps keep the team healthy and winning!
Formaldehyde contamination
Thank you so much for installing the REME HALO Air Purification System on our home. We were in a desperate situation to find a way to decontaminate our home from a formaldehyde contamination. New furnishings we had purchased May 1, 2015 was highly contaminated with formaldehyde and remained in our home for two months before we realized it’s toxicity had infiltrated our home and had caused sever health issues with my wife. My wife’s face, neck, chest, arms and hands became highly inflamed and then infected, the doctors told her that her home was still contaminated and that is why it would not heal. When we told Russell of our crisis with our home and health he and Ryan were immediately at our door the next morning. Ryan made a simple attachment to our existing furnace system of the HALO filter within an hour. He stated that within 5-7 days we would see an improved difference Within 48 hours we could tell a difference in the toxicity in the home and within a week the home air quality was very much improved. My wife began to see a significant healing with her burned skin and skin infection by two weeks. Her doctor was amazed at her quickened improvement. We are positive it is in part because of the HALO filter system. We gladly placed in our doctors hands information on the HALO system. He was very impressed. What Russell and Ryan R. stated the system could perform is exactly what occurred, within the exact time period. We highly recommend this system to anyone who is seeking an air purifier for their home.
— Sincerely, V and J H.
Read More